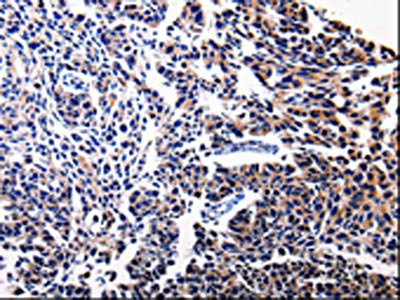

BIRC5 Antibody
-
中文名稱:BIRC5兔多克隆抗體
-
貨號(hào):CSB-PA159155
-
規(guī)格:¥1100
-
圖片:
-
其他:
產(chǎn)品詳情
-
Uniprot No.:
-
基因名:
-
別名:API4 antibody; Apoptosis inhibitor 4 antibody; Apoptosis inhibitor survivin antibody; Apoptosis inhibitor4 antibody; Baculoviral IAP repeat containing 5 antibody; Baculoviral IAP repeat containing protein 5 antibody; Baculoviral IAP repeat-containing protein 5 antibody; BIRC 5 antibody; BIRC5 antibody; BIRC5_HUMAN antibody; EPR 1 antibody; IAP4 antibody; Survivin variant 3 alpha antibody; SVV antibody; TIAP antibody
-
宿主:Rabbit
-
反應(yīng)種屬:Human,Mouse,Rat
-
免疫原:Fusion protein of Human BIRC5
-
免疫原種屬:Homo sapiens (Human)
-
標(biāo)記方式:Non-conjugated
-
抗體亞型:IgG
-
純化方式:Antigen affinity purification
-
濃度:It differs from different batches. Please contact us to confirm it.
-
保存緩沖液:-20°C, pH7.4 PBS, 0.05% NaN3, 40% Glycerol
-
產(chǎn)品提供形式:Liquid
-
應(yīng)用范圍:ELISA,IHC
-
推薦稀釋比:
Application Recommended Dilution ELISA 1:1000-1:5000 IHC 1:25-1:100 -
Protocols:
-
儲(chǔ)存條件:Upon receipt, store at -20°C or -80°C. Avoid repeated freeze.
-
貨期:Basically, we can dispatch the products out in 1-3 working days after receiving your orders. Delivery time maybe differs from different purchasing way or location, please kindly consult your local distributors for specific delivery time.
-
用途:For Research Use Only. Not for use in diagnostic or therapeutic procedures.
相關(guān)產(chǎn)品
靶點(diǎn)詳情
-
功能:Multitasking protein that has dual roles in promoting cell proliferation and preventing apoptosis. Component of a chromosome passage protein complex (CPC) which is essential for chromosome alignment and segregation during mitosis and cytokinesis. Acts as an important regulator of the localization of this complex; directs CPC movement to different locations from the inner centromere during prometaphase to midbody during cytokinesis and participates in the organization of the center spindle by associating with polymerized microtubules. Involved in the recruitment of CPC to centromeres during early mitosis via association with histone H3 phosphorylated at 'Thr-3' (H3pT3) during mitosis. The complex with RAN plays a role in mitotic spindle formation by serving as a physical scaffold to help deliver the RAN effector molecule TPX2 to microtubules. May counteract a default induction of apoptosis in G2/M phase. The acetylated form represses STAT3 transactivation of target gene promoters. May play a role in neoplasia. Inhibitor of CASP3 and CASP7. Essential for the maintenance of mitochondrial integrity and function. Isoform 2 and isoform 3 do not appear to play vital roles in mitosis. Isoform 3 shows a marked reduction in its anti-apoptotic effects when compared with the displayed wild-type isoform.
-
基因功能參考文獻(xiàn):
- NF-kappaB activation may infer resistance to apoptosis through the expression of anti-apoptotic genes such as Survivin, which showed progressive increase in expression throughout the oesophageal metaplasia-dysplasia-adenocarcinoma sequence. PMID: 29473241
- Study demonstrate that ZIC1 plays a tumor suppressive role in breast cancer, by targeting surviving, significantly downregulating its expression. PMID: 29956756
- Studying survivin expression in leukocytes of 144 female rheumatoid arthritis patients this study observed that smoking patients had higher survivin transcription and a remarkable spreading of survivin isoforms. PMID: 27915033
- Our findings identify survivin as a target of HO-1 and a mediator of adipocyte-induced survival in the metastatic niche. PMID: 29311669
- High BIRC5 expression is associated with gefitinib resistance in lung cancer. PMID: 30106446
- miR-203 expression also inhibited primary tumor growth in ovaries and metastatic tumors in multiple peritoneal organs including liver and spleen. miR-203 inhibits ovarian tumor metastasis by targeting BIRC5/survivin and attenuating the TGFbeta pathway. PMID: 30241553
- Survivin may be implicated in the bcl-2 and p53 pathways and therefore in the biology of PDAC. Its potential use as a survival predictor and therapeutic target represent a promising field. PMID: 30249893
- Study in hepatocellular carcinoma cell line elicited a new mechanism in which IGF-1 induced epithelial-mesenchymal transition through regulation of survivin and a downstream pathway. PMID: 29989646
- In the present study, liposomeplasmid DNA encoding mutant survivinT34A could inhibit tumor growth of cervical cancer. This inhibition may be associated with an increase in the apoptosis rate of tumor cells and a reduction in angiogenesis. PMID: 29767242
- simvastatin significantly inhibited the proliferation and invasion of SACC83 cells, induced apoptosis, and reduced the expression of survivin, which suggests that simvastatin may be a novel target for salivary gland adenoid cystic carcinoma therapy. PMID: 29956779
- Survivin is significantly up-regulated in hepatocellular carcinoma (HCC)tissues and associated with tumor growth and lymph node metastasis. Clinical detection of survivin level combined with MRI examination might be beneficial for clinical diagnosis and treatment of HCC PMID: 30010107
- Our study identified the STAT3 rs1053004 C/C as a high-risk genotype in MA with lower survivin and VEGF transcription levels in the peripheral blood. PMID: 30226700
- Overexpression of miR-485-5p suppresses breast cancer progression and enhances chemosensitivity. Further study demonstrated that miR-485-5p directly targeted the 3'-untranslated region of survivin and overexpression of survivin overcomes the miR-485-5p induced effects on breast cancer. PMID: 29678577
- Survivin expression in gastric cancer cells is regulated by DEC1. PMID: 29204860
- High serum survivin levels with GG genotype are associated with Brain Tumors. PMID: 30275230
- LNC473 could recruit deubiquitinase USP9X to inhibit the ubiquitination level of survivin and then increase survivin expression. PMID: 29605299
- Oct4 plays a vital role in the malignant progression of HCC cells through the survivin/STAT3 signaling pathway. PMID: 29901157
- Our study results may suggest that high serum survivin levels can show 4 times increased risk of cancer in a subject with a high suspicion of cancer. Furthermore, survivin level was not influenced with demographic characteristics of breast, gastric, colorectal, prostate, ovarian cancer, and glioblastome multiforme. PMID: 29893319
- These findings collectively suggest that the triple combination of survivin knockdown with ABT-263 and trametinib treatment, may be a potential strategy for the treatment of KRAS-mutant lung adenocarcinoma. Furthermore, our findings indicate that the welldifferentiated type of KRAS-mutant lung tumors depends, at least in part, on TTF1 for growth. PMID: 29658609
- Targeting the Cripto-1/TAK-1/NF-kappaB/Survivin pathway may be an effective approach to combat apoptosis resistance in cancer. PMID: 29807222
- suggests SIRT1 may serve as a predictor of poor prognosis in esophageal squamous cell carcinoma, and its mediated tumor-promoting role might be associated with the overexpression of EGFR protein in esophageal squamous cell carcinoma PMID: 29625788
- CSN5 directly bound survivin and decreased its ubiquitination to enhance the protein stability of survivin. PMID: 29596838
- The survivin gene 3' UTR polymorphisms (rs17878624) show that GG genotype provides substantial protection from non-small-cell lung carcinoma. PMID: 29631694
- Concomitant high expression of survivin and VEGF-C is closely associated with LNM status of PTC patients, which suggests their cooperation in the metastatic process. PMID: 29578160
- In leukoplakia, the expression of survivin associated with that of ki-67 reinforces the assumption that all these lesions are potentially malignant. PMID: 28346726
- Study showed for the first time that the suppression of rheumatiod arthritis fibroblast-like synoviocyte was mediated by phosphatase and tensin homolog involving survivin silencing. PMID: 28337018
- ERCC1 expression may also inhibit esophageal squamous cell carcinoma cell apoptosis via regulating survivin expression, and ERCC1 and survivin overexpression are independent predictors of prognosis for ESCC patients who receive chemotherapy and/or radiotherapy PMID: 30075571
- let-7b targets PLK1 to inhibit hepatocellular carcinoma cell growth and induce their apoptosis by attenuating the PLK1-mediated Survivin phosphorylation PMID: 29913237
- Overexpression of Survivin in glioma cells induces chromosomal instability PMID: 29282022
- High BIRC5 expression is associated with ovarian cancer. PMID: 29795564
- In III-rd trimester of pregnancy parameters of Timp-1 and Survivin - anti-apoptotic substances concentration were similar in maternal and cord blood in both artery and vein. We found no increased activity of selected antiapoptotic factors. PMID: 28509321
- Results form study in non-small-cell lung cancer cells showed that SphK2 plays a critical role in doxorubicin-induced resistance by regulating key anti-apoptotic gene, survivin. PMID: 28950390
- Survivin overexpression plays a key role in the chemoresistance of ovarian CSCs. PMID: 30061219
- Survivin may play an important role in the occurrence and development of laryngeal carcinoma, and its high expression is related to the poor prognosis of patients with laryngeal cancer. (Meta-analysis) PMID: 29270761
- treatment of DLD1 cells with tamoxifen , betaestradiol, or a combination of these two drugs, inhibited cell viability and migration, promoted cell apoptosis, and reduced the mRNA and protein expression levels of survivin in a dose and timedependent manner. These results provide novel experimental basis for hormonal adjuvant therapy for the treatment of colorectal cancers PMID: 28849238
- Studies indicated that high survivin expression in renal cell carcinoma (RCC) was associated with poor overall survival [Review]. PMID: 27411378
- Nuclear accumulation of survivin is associated with proliferative phenotype and was shown to be a worse prognostic marker in breast ductal carcinoma. PMID: 29517199
- Knockdown of BIRC5, a member of the inhibitor of apoptosis protein family, using either lentiviral vector based CRISPR/Cas9 nickase gene editing or inhibition of survivin using the small-molecule inhibitor YM155, results in the suppression of epithelial to mesenchymal transition in retinal pigment epithelial cells. PMID: 29522718
- By downregulation of Sp1 and survivin at the late phase of treatment. PMID: 28713892
- The expressions of survivin and STAT2 are up-regulated in skin lesions of PV patients, and their mRNA expressions are positively correlated. PMID: 29089085
- Findings suggest that lysosome-associated transmembrane protein 4B (LAPTM4B), vascular endothelial growth factor (VEGF), and nuclear survivin expression are significantly correlated in breast cancer, which may be predictive of prognosis as well as effective therapeutic targets for anticancer therapies. PMID: 28476037
- HIF-2alpha dictates the resistance of human pancreatic cancer cells to TRAIL under normoxic and hypoxic conditions and transcriptionally regulates survivin expression. PMID: 28476028
- survivin may have a role in recurrence in rectal cancer patients treated with surgery and postoperative concurrent chemo-radiation therapy PMID: 27391438
- Results identified BIRC5 to be significantly upregulated in the lung squamous cell carcinoma tissues of smoking patients and may play an important role in diagnosis and prognosis. PMID: 28949095
- After cancer cell fusion, some fused cells avoid the apoptotic crisis partly owing to survivin, and continue to proliferate, a process that contributes to human cancer progression. PMID: 28193315
- High survivin expression is associated with lung cancer and colorectal cancer. PMID: 27602754
- Data suggest that Ki-67 index and survivin may be useful biomarkers for rectal cancer with preoperative chemoradiotherapy. PMID: 29491110
- inhibition of apoptosis targeting survivin might represent an effective strategy for both obesity and cancer therapy. PMID: 28518147
- FAT10 promotes tumor proliferation by directly stabilizing Survivin protein in breast cancer cells. PMID: 27806337
- nuclear survivin is a prognostic marker for the progression of oral squamous cell carcinomas. PMID: 28384094
顯示更多
收起更多
-
亞細(xì)胞定位:Cytoplasm. Nucleus. Chromosome. Chromosome, centromere. Cytoplasm, cytoskeleton, spindle. Chromosome, centromere, kinetochore. Midbody.
-
蛋白家族:IAP family
-
組織特異性:Expressed only in fetal kidney and liver, and to lesser extent, lung and brain. Abundantly expressed in adenocarcinoma (lung, pancreas, colon, breast, and prostate) and in high-grade lymphomas. Also expressed in various renal cell carcinoma cell lines. Ex
-
數(shù)據(jù)庫(kù)鏈接:
Most popular with customers
-
-
YWHAB Recombinant Monoclonal Antibody
Applications: ELISA, WB, IHC, IF, FC
Species Reactivity: Human, Mouse, Rat
-
Phospho-YAP1 (S127) Recombinant Monoclonal Antibody
Applications: ELISA, WB, IHC
Species Reactivity: Human
-
-
-
-
-